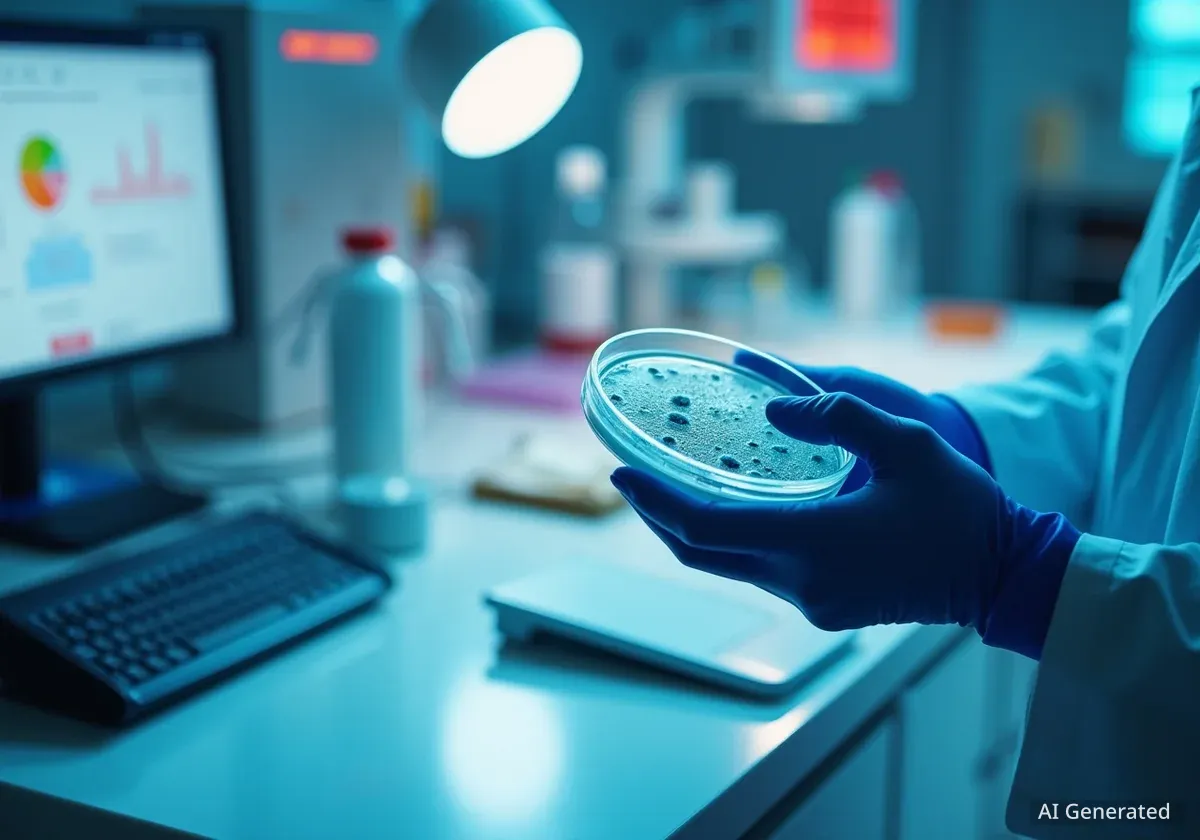
Chiesi presenta avances en medicina respiratoria personalizada

Patricia Ruiz
Patricia Ruiz es una periodista especializada en educación superior y políticas universitarias. Su trabajo se enfoca en analizar las tendencias pedagógicas, la satisfacción estudiantil y los desafíos de la formación profesional en España.